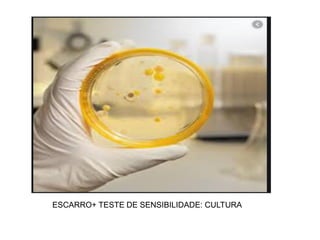
ESCARRO+ TESTE DE SENSIBILIDADE: CULTURA

O documento aborda o cuidado de enfermagem em relação à tuberculose, destacando suas características, transmissão e fatores de risco associados. A tuberculose é uma doença infecciosa prevenível e tratável que se espalha principalmente pelo ar, afetando o pulmão e podendo levar à infecção latente. O tratamento da tuberculose deve ser diretamente observado para garantir a adesão, especialmente em populações vulneráveis.